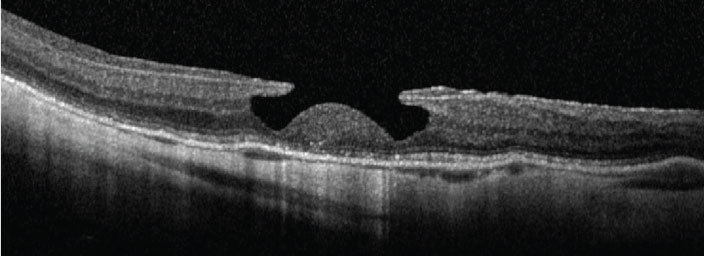

![]() |
|
Bios Dr. Felfeli is an ophthalmology resident at the University of Toronto. Dr. Grinton is a medical retina fellow at University Health Network, Toronto. Dr. Mandelcorn is an DISCLOSURES: The authors have no relevant financial disclosures. |
Optical coherence tomography has evolved considerably over the last decades and the literature in that time has described many distinct OCT terminologies. In addition to serving a significant diagnostic role, OCT can enable better prognostication of patient outcomes and also inform operative decision-making.
A good understanding of OCT patterns is essential in vitreoretinal practice where what we see on OCT may guide our surgical decision-making. Here, we summarize the top 10 OCT terminologies that are relevant in the context of vitreoretinal surgery.
1. Disorganization of retinal inner layers (DRIL)
DRIL is an OCT pattern that involves the inner nuclear layer, outer plexiform layer (OPL) and ganglion cell-inner plexiform layer complex (Figure 1). Specifically, these layers aren't distinguishable on OCT.1
![]() |
|
Figure 1. In disorganization of retinal inner layers (DRIL), the boundaries of the retinal layers are indistinguishable on optical coherence tomography. (Images by the authors except where noted) |
Greater DRIL extent in patients with epiretinal membrane has been associated with poorer outcomes following pars plana vitrectomy, which we should take into consideration when we’re discussing the visual prognosis in patients undergoing ERM surgery.2
2. INL microcysts
INL microcysts (Figure 2) are cystic, hyporeflective spaces generally observed in the INL in eyes affected with conditions such as ERM that result in macular edema.3 The formation of INL microcysts following ERM peel is common and predicts poor postoperative visual outcomes. Additionally, unlike cystoid macular edema, INL microcysts don’t respond to intravitreal steroids and shouldn’t be treated in patients with these findings following ERM peel.4
![]() |
|
Figure 2. Inner nuclear layer microcysts, shown as cystoid changes in the orange INL. |
3. Cotton ball sign (CBS)
CBS (Figure 3) is a round, hyperreflective region that’s observed between the interdigitation zone (IZ) and ellipsoid zone.5 The presence of CBS is strongly associated with ERM presence and vitreomacular traction. Importantly, when the tractional forces on the fovea are released, the CBS is no longer observable on OCT.5
CBS may predict future decline in visual acuity because it indicates significant foveal traction. However, the presence of CBS doesn’t necessarily mean that the patient has poor visual acuity because this pattern can be observed in patients with relatively good VA.5
![]() |
Figure 3. Cotton ball sign appears as a round, hyperreflective region between the ellipsoid zone (EZ, lowest blue layer) and interdigitation zone (IZ, yellow layer toward bottom). |
4. Foveal crack sign (FCS)
FCS (Figure 4) appears on OCT as a vertical, hyperreflective line in the foveola.6 Clinicians should be aware of this sign because it’s uniquely associated with macular hole formation following PPV for rhegmatogenous retinal detachment. Specifically, Tomoyuki Ishibashi, MD, and colleagues in Japan observed FCS in 100 percent of eyes that developed a secondary macular hole following PPV for RRD.6
They observed FCS on OCT at 255 ± 217 days following PPV, and macular hole development at 232 ± 171 days following FCS appearance, indicating that these patients should be followed longer term following RD repair.
![]() |
|
Figure 4. Foveal crack sign manifests as a vertical, hyperreflective line in the foveola (arrow). (From: Ishibashi T, Iwama Y, Nakashima H, Ikeda T, Emi K. Foveal crack sign: An OCT sign preceding macular hole after vitrectomy for rhegmatogenous retinal detachment. Am J Ophthalmol. 2020;218:192-198. Used with permission.) |
5. Epiretinal membrane staging
Andrea Govetto, MD, and colleagues were the first to offer a standardized, OCT-based description of the relevant ERM stages.7 Clinically speaking, this classification system is useful in assessing overall severity and prognosticating patient outcomes. The stages are:
- Stage 1. In this stage, ERM (Figure 5A), the foveal depression is generally preserved. Additionally, the individual retinal layers are preserved and can be distinguished easily.
- Stage 2. The retinal layers can still be readily distinguished in this stage (Figure 5B). However, the foveal depression isn’t present and the ONL is commonly widened.
- Stage 3. This stage (Figure 5C) is characterized by the absence of the foveal depression and presence of well-
defined layers of the retina. However, the presence of ectopic inner foveal layers (EIFL) is a central feature of stage 3 ERM. EIFL is associated with worse outcomes following PPV in patients with ERM.8 - Stage 4. Stage 4 ERM (Figure 5D) retains the same features as stage 3 (absence of foveal depression, EIFL), with one key exception: the retinal layers can’t be clearly determined. Also, retinal thickening is typically observed in stage 4.
As these ERM stage progress, postoperative outcomes tend to be poorer as the macular architecture continues to worsen (e.g., EIFL presence). Ultimately, the decision to operate will depend on several factors, such as ERM stage, preoperative VA and degree of metamorphopsia.
![]() |
Figure 5. The four stages of epiretinal membrane: A) stage 1; B) stage 2; C) stage 3; and D) stage 4. (From: Govetto A, Lalane RA 3rd, Sarraf D, Figueroa MS, Hubschman JP. Insights into epiretinal membranes: Presence of ectopic inner foveal layers and a new optical coherence tomography staging scheme. Am J Ophthalmol. 2017;175:99-113. Used with permission.) |
6. Tractional lamellar hole
Tractional lamellar holes (Figure 6) form when the OPL and ONL separate. On OCT, this pattern can be readily identified due to its moustache-like appearance. Tractional lamellar holes are typically observed in eyes with ERM and VMT.9 Vision is generally good despite the presence of tractional lamellar hole,9 likely because the photoreceptor-RPE interface isn’t disturbed.
![]() |
|
Figure 6. Tractional lamellar hole, readily identifiable by its moustache-like appearance. (From: Govetto A, Dacquay Y, Farajzadeh M, et al. Lamellar macular hole: Two distinct clinical entities? Am J Ophthalmol. 2016;164:99-109. Used with permission.) |
7. Degenerative lamellar hole
Several features characterize degenerative lamellar holes (Figure 7), including a central cavitation that may involve the layers of the outer retina, foveal bump, and EZ disruption.
In contrast to the moustache-like appearance of tractional lamellar holes, degenerative lamellar holes have a top-hat like appearance. Most degenerative lamellar holes are also associated with the presence of epiretinal proliferation.9 Similar to tractional lamellar holes, these cases are often observed.
![]() |
|
Figure 7. Degenerative lamellar hole, characterized by central cavitation. (From: Govetto A, Dacquay Y, Farajzadeh M, et al. Lamellar macular hole: Two distinct clinical entities? Am J Ophthalmol. 2016;164:99-109. Used with permission.) |
8. Macular pseudohole
The main features of macular pseudoholes (Figure 8) include fovea-sparing ERM, retinal thickening and vertical foveal edges.10,11 The mechanism of macular pseudohole formation is thought to be due to centripetal ERM contraction.
![]() |
|
Figure 8. Macular pseudohole is thought to be due to centripetal epiretinal membrane contraction. |
9. Needle sign
Needle-shaped deposits on the retina surface characterize the needle sign (Figure 9). This sign is typically observed in eyes that have previously undergone PPV and, more rarely, in cases of ocular amyloidosis.12
![]() |
Figure 9. Needle sign, as evidenced by needle-shaped deposits on the retinal surface. |
10. Omega sign (II)
Retention of perfluorocarbon (PFCL) bubbles following PPV can lead to the subsequent accumulation of PFCL in the subretinal space. This can result in a bubble with a dome-shaped appearance, called the omega sign (Figure 10).
If this occurs in the subfoveal space, the PFCL should be removed to avoid long-term damage to the photoreceptors.13
![]() |
|
Figure 10. Omega sign, caused by retention of perfluorocarbon bubbles. (Courtesy Nicolas Yannuzzi, MD, and Jayanth Sridhar, MD) |
Bottom line
Here, we provide a brief summary of OCT terminology that vitreoretinal surgeons encounter in practice. We should be aware of these subtle changes on OCT to help us in deciding whether to offer surgery to patients. Understanding their nuances can help guide our surgical decision-making. RS
REFERENCES
1. Sun JK, Lin MM, Lammer J, et al. Disorganization of the retinal inner layers as a predictor of visual acuity in eyes with center-involved diabetic macular edema. JAMA Ophthalmol. 2014;132:1309-1316.
2. Zur D, Iglicki M, Feldinger L, Schwartz S, Goldstein M, Loewenstein A, Barak A. Disorganization of retinal inner layers as a biomarker for idiopathic epiretinal membrane after macular surgery—The DREAM study. Am J Ophthalmol. 2018;196:129-135.
3. Brar M, Yuson R, Kozak I, et al. Correlation between morphologic features on spectral-domain optical coherence tomography and angiographic leakage patterns in macular edema. Retina. 2010;30:383-389.
4. Chen SJ, Tsai FY, Liu HC, Chung YC, Lin TC. Postoperative inner nuclear layer microcysts affecting long-term visual outcomes after epiretinal membrane surgery. Retina. 2016;36:2377-2383.
5. Tsunoda K, Watanabe K, Akiyama K, Usui T, Noda T. Highly reflective foveal region in optical coherence tomography in eyes with vitreomacular traction or epiretinal membrane. Ophthalmology. 2012;119:581-587.
6. Ishibashi T, Iwama Y, Nakashima H, Ikeda T, Emi K. Foveal Crack Sign: An OCT sign preceding macular hole after vitrectomy for rhegmatogenous retinal detachment. Am J Ophthalmol. 2020;218:192-198.
7. Govetto A, Lalane RA 3rd, Sarraf D, Figueroa MS, Hubschman JP. Insights into epiretinal membranes: Presence of ectopic inner foveal layers and a new optical coherence tomography staging scheme. Am J Ophthalmol. 2017;175:99-113.
8. Govetto A, Virgili G, Rodriguez FJ, Figueroa MS, Sarraf D, Hubschman JP. Functional and anatomical significance of the ectopic inner foveal layers in eyes with idiopathic epiretinal membranes: Surgical results at 12 months. Retina. 2019;39:347-357.
9. Govetto A, Dacquay Y, Farajzadeh M, et al. Lamellar macular hole: Two distinct clinical entities? Am J Ophthalmol. 2016;164:99-109.
10. Michalewski J, Michalewska Z, Dzigielewski K, Nawrocki J. Evolution from macular pseudohole to lamellar macular hole—Spectral domain OCT study. Graefes Arch Clin Exp Ophthalmol. 2011;249:175-178.
11. Hubschman JP, Govetto A, Spaide RF, et al. Optical coherence tomography-based consensus definition for lamellar macular hole. Br J Ophthalmol. 2020;104:1741-1747.
12. Kakihara S, Hirano T, Matsuda Y, et al. Deposits on retinal surface seen on OCT in ocular amyloidosis. Ophthalmol Retina. 2021;5:1005-1008.
13. Figueroa MS, Contreras I. Characteristics of retained subretinal perfluoro-n-octane on optical coherence tomography. Retina. 2012;32:2177-2178.